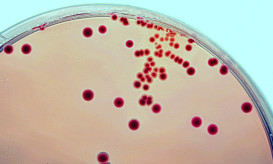

Κεραυνοβόλος μηνιγγίτιδα: Πώς μεταδίδεται και γιατί χορηγείται επειγόντως χημειοπροφύλαξη
Πόσοι είναι οι φορείς του υπαίτιου βακτηρίου, για πόσο καιρό είναι μεταδοτικοί και πόσο κινδυνεύει ο περίγυρός τους.

Πόσοι είναι οι φορείς του υπαίτιου βακτηρίου, για πόσο καιρό είναι μεταδοτικοί και πόσο κινδυνεύει ο περίγυρός τους.

Ποια μορφή είναι πιο επικίνδυνη και ποιοι κινδυνεύουν περισσότερο να την εκδηλώσουν. Η σημασία του χρόνου.

Τι αναφέρουν βρετανοί ειδικοί. Πότε να πάτε επειγόντως στο νοσοκομείο. Πότε να ζητήσετε νέα ιατρική συμβουλή.

Το 1987, δεκάδες χιλιάδες άνθρωποι μαζεύτηκαν στη Σαουδική Αραβία για το ετήσιο προσκύνημα Hajj. Ωστόσο, αυτό που ξεκίνησε ως...

Μηνιγγίτιδα είναι ένας όρος που χρησιμοποιείται για να περιγράψει μια φλεγμονή των μεμβρανών που περιβάλλουν τον εγκέφαλο, ή το...

Ένα εξάνθημα που δεν υποχωρεί (“εξαφανίζεται” όταν του ασκείτε πίεση είναι ένα σημάδι μηνιγγοκοκκικής σηψαιμίας (μηνιγγοκοκκικά βακτήρια μπορεί να...

Μηνιγγίτιδα είναι η φλεγμονή των μεμβρανών (μήνιγγες) που περιβάλλουν τον εγκέφαλο και το νωτιαίο μυελό.

Η μηνιγγίτιδα είναι μια κατάσταση που προκαλεί φλεγμονή στα μηνίγγια, τα οποία προστατεύουν τον εγκέφαλο και το νωτιαίο μυελό....

Ο απότομος πυρετός, η αυχενική δυσκαμψία, το μειωμένο επίπεδο συνείδησης ή/και το διάχυτο εξάνθημα στο δέρμα μπορεί να υποκρύπτουν...
Η μηνιγγίτιδα αποτελεί αιφνίδια λοίμωξη και τον χειρότερο εφιάλτη του ιατρού και του γονέα. Έχει απρόβλεπτη έναρξη, ενώ μπορεί...

Σήμερα ξεκίνησε μια νέα εκστρατεία ενημέρωσης από τα κεντρικά της GSK με τον αντιπροσωπευτικό τίτλο Mums Vs Meningitis, η...

Η 24η Απριλίου γιορτάζεται κάθε χρόνο ως η Παγκόσμια Ημέρα Μηνιγγίτιδας. Η μηνιγγίτιδα, κυρίως η βακτηριακή μηνιγγίτιδα, είναι μία...

Έγκριση υπήρξε στην Ευρωπαϊκή Ένωση για τη χορήγηση του του συζευγμένου εμβολίου κατά του μηνιγγιτιδόκοκκου ομάδας A, C, W-135...

Έντονη ανησυχία έχει προκληθεί στους γονείς εξαιτίας των κρουσμάτων μηνιγγίτιδας που εκδηλώθηκαν πρόσφατα φέρνοντας και πάλι στην επιφάνεια το...